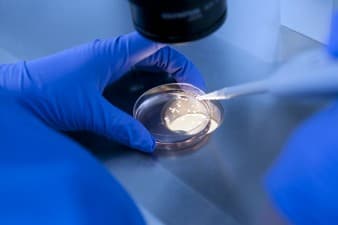
Ingenes Instituto de Fertilidad y Genética

Egg Freezing in Mexico
Search and Compare the Best Clinics and Doctors at the Lowest Prices for Egg Freezing in Mexico

Find the best clinics for Egg Freezing in Mexico
No clinics available

From 10 verified reviews
alvina magaña velazquez, 30 April 2020
The truth is that it is a beautiful experience and at the same time you give that opportunity to be parents who cannot bring a smile to your family and love to your lives.
From 1 verified reviews
Gloria Vizcaino, 03 December 2013
Hello good morning Dr. Everything happens for the good of those who love God who hire me from the Grupo Corona u TONAYAN company and Daniel Arreola naturist center of El Grullo Jalisco
From 79 verified reviews
Aaronl Lopez Rivera, 28 July 2020
I worked there in 1994 it was my first job at that time so it was very cleanIt was when Juan Tabarez of the liberation group was internedAnd Lic Joel Manzina hired meVery good personThen he went to the Santa Engracia hospitalWas or is in the same hospitalI have not heard from him
From 19 verified reviews
Jose luis Chavez, 24 January 2020
Very good treatment and they are very professional
From 19 verified reviews
Jose luis Chavez, 07 January 2020
Very good treatment and they are very professional
From 137 verified reviews
Yeanlis Rivas, 12 September 2020
Hello, I had an invitation treatment with Dr. Santiago ...... very happy and satisfied with her excellent work. Through this means, I would like to communicate with the Dr. to tell her that it was a complete success. My babies are big and precious. Communicate with Dr. Y.Santiago since I live in the US, it has been difficult for me to communicate with her ..... many blessings and success to Dra in her career and to all the families who start their best experience
CEFAM Surrogacy, located in Alvaro Obregon, Mexico City, Mexico offers patients Egg Freezing procedures among its total of 1 available procedures, across 1 different specialties. Currently, there's no pricing information for Egg Freezing procedures at CEFAM Surrogacy, as all prices are available on request only, whilst the national average price is approximately $3,057. There are many specialists available at the Hospital, with 4 in total, and they have multiple recognized accreditations, including: CMGO - Consejo Mexicano de Ginecología y ObstetriciaSEF - Sociedad Española De FertilidadASRM - American Society for Reproductive MedicineAMMR - Asociación Mexicana de Medicina de la ReproducciónAFA - American Fertility Association
Irega Cancun, located in Blvd Kukulcan, Cancun, Mexico offers patients Egg Freezing procedures among its total of 5 available procedures, across 1 different specialties. The cost of a Egg Freezing procedure starts from Price on request, whilst the national average price is approximately $3,057. There are many specialists available at the Hospital, with 9 in total, and they have multiple recognized accreditations, including: CMGO - Consejo Mexicano de Ginecología y ObstetriciaThe Joint Commission Accreditation ProgramAMMR - Asociación Mexicana de Medicina de la Reproducción
- Home
- Mexico
WHY US?
At Medijump, we're making medical easy. You can search, compare, discuss, and book your medical all in one place. We open the door to the best medical providers worldwide, saving you time and energy along the way, and it's all for FREE, no hidden fees, and no price markups guaranteed. So what are you waiting for?

Free

Best Price

Widest Selection

Risk-Free
What you need to know about Egg Freezing in Mexico

Egg Freezing, also known as Oocyte Cryopreservation, is a way of preserving a patient’s fertility so she can try to have a family in the future. It involves collecting eggs, freezing them and then thawing them later on so they can be used for fertility treatment.
Some patients freeze their eggs because they have a medical condition or are undergoing treatment that affects their fertility. It can also be used by women who aren’t ready or able to have children and want the chance of conceiving in the future. When you go for your initial consultation and evaluation with the specialist, ask questions regarding success rates and the risks involved.
You will need to be tested for any infectious diseases like HIV and Hepatitis. This has no bearing on whether you can freeze your eggs, it is to ensure that affected egg samples are stored separately to prevent contamination of other samples.
You'll then start the IVF (In vitro fertilization) process, which usually takes around two to three weeks to complete. Normally this will involve taking drugs to boost your egg production and help the eggs mature. When they’re ready, they’ll be collected whilst you’re under general anesthetic or sedation using an ultrasound-guided probe. The needle attached will pass through the vaginal wall and into the ovary, where it will draw the eggs. This can take less than 20 minutes and you can there is no need for overnight stay.
At this point, instead of mixing the eggs with sperm (as in conventional IVF) a cryoprotectant (freezing solution) will be added to protect the eggs. The eggs will then be frozen either by cooling them slowly or by vitrification (fast freezing) and stored in tanks of liquid nitrogen.
What is the cost of Egg Freezing in Mexico?
Egg Freezing constitutes a considerable commitment in terms of time and financial resources. The associated expenses might encompass fees for preliminary examinations, ovarian stimulation, egg collection, and extended storage. These costs can significantly fluctuate based on the clinic chosen and its geographical location. Additionally, hidden expenditures such as travel and lodging should be taken into account, especially if the procedure is carried out in a distant city or foreign country. Furthermore, the financial calculation should also incorporate potential subsequent costs like the defrosting process and embryo transplantation when deciding to utilize these eggs.
What are the conditions to undergo Egg Freezing?
Most patients will have around 15 eggs collected although this isn’t always possible for those with low ovarian reserves (low numbers of eggs). When you want to use them, the eggs will be thawed and must be fertilized using a fertility treatment called ICSI, as the freezing process makes the outer coating around the eggs tougher and sperm may be unable to penetrate it naturally under IVF.
You’ll need to complete consent forms before you start treatment specifying how you want your eggs to be used. This includes information on how long you want the eggs to be stored for (the standard period is 5 - 10 years), what should happen to your eggs if you were to die or become unable to make decisions for yourself, whether the eggs are to be used for your own treatment only, or whether they can be donated for someone else’s treatment, or used for research or training if you don't want to use them or any other conditions you may have for the use of your eggs.
Whilst egg freezing is a great option if you're approaching 40 and not yet ready to have a child/children but you're keen to in the future, it is also considered the solution to some medical conditions or circumstances that may affect your fertility, such as:
- Ovarian disease with risks that may damage your ovaries.
- A genetic mutation that may require removing your ovaries.
- Surgery that may damage your ovaries.
- If you have cancer that requires chemotherapy and/or pelvic radiation therapy (these may affect your fertility).
- Chromosomal abnormalities - poses risks of premature ovarian failure.
Unlike fertilized egg freezing or embryo cryopreservation, this form of the procedure will not require sperm because your eggs will not be fertilized before being frozen.
If you are considering freezing your eggs, note that the medical professionals you'll be dealing with are Reproductive Endocrinologists. Generally, you will be able to acquire the healthiest eggs before you reach 30, the younger you are, the better, simply because at a younger age you will be able to produce and freeze more eggs in one cycle.
What does a Egg Freezing Procedure Involve?
Before you begin your egg freezing process, you need to first undergo a series of blood tests as an assessment, these include:
- Infectious disease screening - this will determine if you have an infectious disease like HIV or Hepatitis to ensure that your affected eggs will be stored separately to prevent them from contaminating the other eggs.
- Ovarian reserve testing - this will determine the quality and quantity of your eggs. The results may also help predict how your ovaries will respond to fertility medications.
You also have to expect that Egg Freezing follows a series of steps; furthermore, egg retrieval will closely follow a similar process to IVF:
Ovarian stimulation - during this first step, you will be given hormonal injection one to several weeks to produce multiple eggs. Your doctor may also give you medications to prevent premature ovulation.
Egg retrieval - this will be done under sedation. Typically, an ultrasound probe will be inserted into your vagina to determine the follicle, a needle will then be guided through your vagina and into the follicle. A suction connected to the needle will be the one to retrieve the eggs from the follicle.
Freezing - after your eggs are harvested, they will now be cooled to a subzero temperature to preserve them for future use.
Although the procedure will differ from country to country and even the hospitals/clinics in Mexico may differ somewhat, but in general, you can expect the following steps carried out over two separate trips:
- Consultation & evaluation with the specialist. Such evaluations may include a physical examination, blood screening (including Thalassemia and serology testing), pelvic examination, cervical cancer screening, and transvaginal ultrasound.
- If everything is clear after the initial consultation & evaluation with the specialist, you will need to come back to Mexico on the second day of your menstrual for a hormone test (FSH & Estrogen).
- You will be prescribed with a medication to be injected daily for 10 days (starting on the second day of the menstrual cycle until the twelfth day of cycle).
- An Ovum pick-up procedure will be performed on the twelfth day of the cycle (this is performed without the need to be present).
- Egg Freezing performed and eggs will be frozen for a pre-determined number of years with the option to unfreeze them at any time.
How Long Should I Stay in Mexico for a Egg Freezing Procedure?
While the process of egg extraction itself can be completed within a single day, the preparatory steps leading to this procedure usually span about 10 to 12 days. It's imperative to consider the preliminary consultations, evaluations carried out before the procedure, and subsequent follow-up sessions, which can substantially prolong the overall timeframe.
Egg retrieval takes roughly about 20 minutes to finish and you will not need any stitches after the procedure since your doctor will not perform any cutting. Just bear in mind that you'll need to plan two separate trips, with the second being timed around your menstrual cycle.
What's the Recovery Time for Egg Freezing Procedures in Mexico?
Typically, the recuperation period following a Egg Freezing is relatively short. The step involving egg extraction during the procedure is carried out while the patient is sedated, typically allowing them to resume routine tasks within one or two days. Nonetheless, it's essential to recognize that each woman's physiology is unique and reactions to such procedures can differ.
You can typically go back to your normal activities, including work and exercise within a week of your egg retrieval. Your doctor will also advise you to avoid having unprotected sex to prevent unintended pregnancy.
What sort of Aftercare is Required for Egg Freezing Procedures in Mexico?
The post-Egg Freezing care aims at mitigating discomfort and expediting recovery. You'll likely be back to your standard routine in a couple of days, but adhering to your healthcare provider's aftercare advice is vital. This advice could encompass techniques to cope with pain, guidance on nutrition, and exercise regulations. Furthermore, paying attention to any physical alterations after the operation and promptly alerting your healthcare provider in case of any concerns is essential. Such concerns could range from intense aches, severe bleeding, or high temperature. Frequent check-ins could significantly contribute to closely tracking your recovery and dealing with any complications swiftly.
The whole process of egg freezing may take between 10 to 14 days. You may freeze your eggs in the long term even for about 10 years.
What's the Success Rate of Egg Freezing Procedures in Mexico?
Given the time when you are ready to have a child, your frozen eggs will be thawed, fertilized with a sperm cell in a lab and then implanted into your uterus or your gestational carrier’s uterus (if in case).
Your chances of getting pregnant after implantation will depend on your age and the time of freezing. It is also important to know that the older you are at the time of your egg freezing, the lower the chances that you’ll achieve childbirth. In addition, your chances of becoming pregnant after implantation are usually about 30% to 60%.
Are there Alternatives to Egg Freezing Procedures in Mexico?
Ovarian Tissue freezing or Ovarian Tissue Banking is one alternative to egg freezing. This is one method of fertility wherein the outer layer of your ovary, which contains a large number of immature eggs, will be taken out of your body and also be frozen for future use.
Another alternative is embryo freezing, typically after IVF treatment, your ovaries are stimulated to produce more eggs and this will be followed by fertilization and embryo culture. There will usually be an excess of good embryos which you can freeze for future use.
What Should You Expect Before and After the Procedure
Before, during, and post-Egg Freezing, being aware of what awaits can help to dispel fears and facilitate planning. Prior to the procedure, anticipate several health checks and evaluations of your ovarian reserve. You will also participate in a hormonal injection plan intended to stimulate your ovaries to yield multiple eggs. The implementation of this plan is meticulously tracked via ultrasounds and blood tests to pinpoint the ideal timeframe for egg extraction. This initial phase involves frequent clinic visits and can be physically and emotionally taxing. Paying attention to your holistic wellbeing through maintaining a nutritious diet, managing stress, and staying physically fit is crucial.
Once the eggs are extracted, they are instantly frozen and preserved. Post-procedure, you might notice slight discomfort, bloating, and potential spotting. However, these symptoms typically vanish within a few days. The majority of women can return to their usual routines within one to two days. Following your healthcare provider's instructions for aftercare is key, and report any worrying signs without delay. Continuing regular clinic visits to track your physical and emotional health is also advisable.
What are Potential Risks of Egg Freezing?
An important thing to know is that Egg freezing also carries several risks, for example:
- Egg retrieval procedure - although a rare occurrence, the use of an aspirating needle to harvest eggs may cause bleeding, infection or damage to your bowel, bladder or blood vessel.
- Emotional risks - although this will give you hope for future pregnancy, achieving success is no guarantee.
- Conditions associated with the use of fertility drugs - fertility drug injectable may cause your ovaries to be swollen and become painful after ovulation or egg retrieval.
Whilst the information presented here has been accurately sourced and verified by a medical professional for its accuracy, it is still advised to consult with your doctor before pursuing a medical treatment at one of the listed medical providers
No Time?
Tell us what you're looking for and we'll reachout to the top clinics all at once
Enquire Now

Popular Procedures in Mexico
Prices Start From $136

Prices Start From $242

Prices Start From $683

Recommended Medical Centers in Mexico for procedures similar to Egg Freezing

- Interpreter services
- Translation service
- Religious facilities
- Medical records transfer
- Medical travel insurance
- Health insurance coordination
- TV in the room
- Safe in the room
- Phone in the room
- Private rooms for patients available

- Interpreter services
- Translation service
- Religious facilities
- Medical records transfer
- Medical travel insurance
- Health insurance coordination
- TV in the room
- Safe in the room
- Phone in the room
- Private rooms for patients available

- Interpreter services
- Translation service
- Religious facilities
- Medical records transfer
- Medical travel insurance
- Health insurance coordination
- TV in the room
- Safe in the room
- Phone in the room
- Private rooms for patients available

- Interpreter services
- Translation service
- Religious facilities
- Medical records transfer
- Medical travel insurance
- Health insurance coordination
- TV in the room
- Safe in the room
- Phone in the room
- Private rooms for patients available

- Interpreter services
- Translation service
- Religious facilities
- Medical records transfer
- Medical travel insurance
- Health insurance coordination
- TV in the room
- Safe in the room
- Phone in the room
- Private rooms for patients available

- Interpreter services
- Translation service
- Religious facilities
- Medical records transfer
- Medical travel insurance
- Health insurance coordination
- TV in the room
- Safe in the room
- Phone in the room
- Private rooms for patients available

- Interpreter services
- Translation service
- Religious facilities
- Medical records transfer
- Medical travel insurance
- Health insurance coordination
- TV in the room
- Safe in the room
- Phone in the room
- Private rooms for patients available

- Interpreter services
- Translation service
- Religious facilities
- Medical records transfer
- Medical travel insurance
- Health insurance coordination
- TV in the room
- Safe in the room
- Phone in the room
- Private rooms for patients available

- Interpreter services
- Translation service
- Religious facilities
- Medical records transfer
- Medical travel insurance
- Health insurance coordination
- TV in the room
- Safe in the room
- Phone in the room
- Private rooms for patients available

- Interpreter services
- Translation service
- Religious facilities
- Medical records transfer
- Medical travel insurance
- Health insurance coordination
- TV in the room
- Safe in the room
- Phone in the room
- Private rooms for patients available
Egg Freezing in and around Mexico
About Mexico
The Country of Mexico forms a part of the North American continent and lies directly south of the United States and is the fifth largest country in the Americas. It comprises 31 states and a Federal District. The capital of Mexico City lies in the Federal District. Mexico is dominated by several mountain ranges and the more well-known ones are the Sierra Madre Oriental and the Sierra Madre Occidental. It is famous for its amazing beaches, and the best-known Latin American pyramids include the Pyramid of the Sun and the Pyramid of the Moon at Teotihuacán in central Mexico,
Mexico ranks among the top five locales for medical tourism worldwide, consistently attracting those seeking not only medical care but luxurious, boutique-styled facilities for recovery as well. The distinct appeal to choosing Mexico as a destination for medical procedures is not solely based on the accommodation standards, but also the notably lower costs contrasted with those in the United States. With a price tag that usually amounts to 70-80% less than what you'd expect to pay in the US for the same procedure, it's no wonder why Mexico is such an attractive option for medical tourists.
In terms of the economic value, medical tourism in Mexico has proven to be no small industry. According to the data gathered in 2016, the industry is worth a whopping $4.8 Billion. Moreover, it is not an underused resource, as can be seen in the influx of medical tourists that the country welcomes each year. An astonishing 1 million individuals travel to Mexico annually, seeking different varieties of treatments and procedures.
Geographically, it's noted that the majority of these medical tourists hail from nearby US states. In fact, states that border Mexico, such as California, Texas, and Arizona, make up approximately 70% of the medical tourists that arrive in Mexico.
Tijuana, Cancun, Mexicali, and Monterrey are some of the more popular cities in Mexico for medical tourism and the flowing procedures:
- Dental treatments including dental surgery
- Plastic and Cosmetic Surgery
- Bariatric Surgery
- Other medical procedures like dermatology, orthopedics, gynecology, and ophthalmology.
Popular Parts of Mexico
Six Cities in Mexico that should be on your itinerary:
- Mexico City – This enormous capital city is the most populous city on the North American continent. The metropolitan area of the city is home to a staggering 21.2 million people. El Zocalo, the main public square is a famous landmark in Mexico City. It is also a UNESCO World Heritage site.
- Cancun –Is a major resort city with turquoise blue waters and striking white sandy beaches. It has a population of about 628,000 people. You can take day trips to the Mayan ruins, the unspoiled jungle habitats of Coba, and Chichen Itza from Cancun.
- San Miguel de Allende –Is one of the most popular cities in Mexico. The must-visit sites in this city are the San Miguel Arcangel Parish, the archaeological zone of Canada la Virgen, and the handicraft market.
- Guadalajara – It’s the second largest city in Mexico and has a population of 5.1 million. The city has a more relaxed feel and a distinctly Mexican flavor. The historic center is impressive with a cathedral and colonial architecture. Guadalajara Cathedral, Instituto Cultural de Cabanas, and the Expiatory Temple are famous sights to visit.
- Oaxaca – Is a southern Mexican city and is situated in a valley. It is home to 4.2 million inhabitants. Oaxaca Cathedral, Zocalo and Mercado Benito Juarez, and The Rufino Tamayo Museum are a few of the interesting places to see in this city.
- Tijuana – Is a border city in Mexico and shares its border with California. Because of its location, this city is very popular with American medical tourists. The Avenida Revolucion is the main street and is lined with Bars and Restaurants. Popular landmarks include Jai Alai Fronton Palace, Centro Cultural Tijuana, and Estadio Caliente. It has a population of 1.3 million people.
Other important cities are Merida, Acapulco, Puebla City, Taxco Puerto Vallarto, and Playa del Carmen.
Weather and Climate in Mexico
Mexico, in its vastness, doesn't possess a uniform climate throughout the nation. Various regions exhibit distinct weather patterns, which are inextricably linked to their geographical features. Given Mexico's immense size, it's unsurprising that the climate varies significantly across different locations. The periodic patterns across the nation are not homogenous, as one would expect in a smaller, less diverse country. Instead, Mexico’s topography, which is incredibly varied, heavily influences the country’s diverse weather and climate.
In terms of seasonality, Mexico traditionally experiences two major seasons - the rainy season and the dry season. Each of these seasons presents its own unique set of conditions and weather patterns, shaping the climate across the country in distinctive ways. The shifts between these periods of rain and periods of drought are quite pronounced, showcasing the climatic dualism that shapes the Mexican landscape. This cyclical pattern of rainy and dry seasons is a key part of Mexico's climatic identity, having profound effects on both its environment and the livelihood of its inhabitants.
- Rainy Season – Most of Mexico experiences rain from May to September or October. The weather is hot and humid in these months, especially in Southern Mexico. The average temperature in the summer months is around 83 degrees Fahrenheit. In winter, the temperature averages between 68- and 74 degrees Fahrenheit.
- Dry Season – October to May there is hardly any rain and it happens to be the most popular time to visit Mexico. During the winter months of December to February, the non-coastal regions have cold weather. At times, it reaches freezing temperatures. June to November is the hurricane season and hence it is better to avoid traveling during this time.
Getting Around in Mexico
The easiest way to reach Mexico is through Mexico City International Airport, which is also referred to as Benito Juarez International Airport, which is the busiest airport in Mexico. The airport links 52 domestic cities and 50 international destinations in Latin America, North America, Europe, and Asia. Aeromexico is the largest carrier serving many Latin American cities, domestic and international cities. Other prominent Mexican airlines are Interjet, Volaris, and Aeromar. Major American carriers like United Airlines, American Airlines, and Delta Air also operate flights to Mexico City.
For travel within Mexico, air travel is the best mode considering the vast size of the country. Budget airlines like Avolar, Azteca, Interjet, vivaAerobus, and Volaris offer competitive and cheap airfares for domestic travel.
You can navigate between cities via local buses and rental cars, making the journey a part of your Mexican adventure. However, for a quicker commute, the metro system prevails as the fastest mode of transport. This web of fast trains bridges the gap between major cities including Mexico City, Guadalajara and Monterrey, ensuring convenient and expedient transportation.
Navigating through Mexico City is fairly simple and cost-effective, courtesy of its inexpensive public transport system. You can choose from a variety of transport modes, including the Metro, first and second-class buses, colectivos, and Nissan Tsuru libre taxis.
However, if you prefer sitio taxis, it is advised not to hail one from the street after dark for safety reasons. Furthermore, for those not fluent in Spanish or unfamiliar with the city's layout, it is highly recommended to use taxis from Taxi Ranks, ensuring a smoother and more secure journey.
Tourist Visas in Mexico
Traveling to Mexico as a tourist, you need to apply for and get a tourist visa well in advance. Your passport must be valid to cover at least three months beyond the duration of your visa. A Mexican tourist visa is for a single entry and is valid for only six months. You should travel within 90 days of the visa being issued.
Mexico has a waiver for the tourist visa requirement for the citizens of 67 countries including the USA, European Union, Latin America, and Australia. Under this privilege, you can visit Mexico for a period of 30 to 180 days without a tourist visa. However, you need to get an online Electronic Authorization before traveling to Mexico.
Nationals of Russia, India China and a few other countries need to get a visa in advance before entering Mexico.
Additional Information
- The currency of Mexico is Peso and has a $ symbol like the US Dollar. So, MXN is an alternative symbol to avoid confusion. Shopkeepers accept US dollars but refuse Euros. The conversion rate of a US dollar to Mexican Peso is 17.97 as of Mexico 2023.
- You can use debit and credit cards within city limits in Mexico, but many retailers levy a surcharge for credit cards. Small shopkeepers insist on cash. ATMs are present everywhere and have bilingual options with English as a choice.
- Spanish is the first and the main language spoken in Mexico. People also speak English in tourist areas and along the Northern border. However, it is always better to learn a little Spanish when you travel to Mexico.
- Mexico does not have a national religion, but Roman Catholicism is a major faith.
- Constitution Day (Feb 4), Benito Juarez’s Birthday (Mar 18), Independence Day (Sep 16), Revolution Day (Nov 18), and Christmas (Dec 25) are some of the statutory public holidays in Mexico.
Popular Searches
- Plastic Surgery in Thailand
- Dental Implants in Thailand
- Hair Transplant in Thailand
- Breast Augmentation Thailand
- Gastric Sleeve in Thailand
- Gender Reassignment Surgery in Thailand
- Laser Hair Removal in Bangkok
- Botox in Bangkok
- Dermatology in Bangkok
- Breast Augmentation in Bangkok
- Coolsculpting in Bangkok
- Veneers in Turkey
- Hair Transplant in Turkey
- Rhinoplasty in Turkey
- Stem Cell Therapy in Mexico
- Rhinoplasty in Mexico
- Liposuction in Mexico
- Coolsculpting in Tijuana
- Rhinoplasty in Korea
- Scar Removal in Korea
- Gastric Sleeve in Turkey
- Bone Marrow Transplant in India
- Invisalign in Malaysia
- Plastic Surgery in the Dominican Republic
- Tummy Tuck in the Dominican Republic
- Plastic and Cosmetic Surgery in Poland
- Rhinoplasty in Poland
- Hair Implant in Poland
- Dental Implants in Poland
- IVF in Turkey